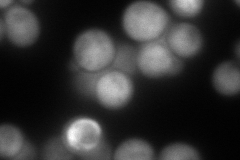
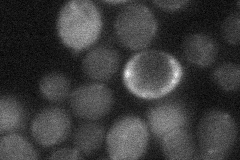
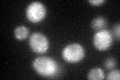
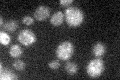

View description
N-myristoylated calcium-binding protein that may have a role in intracellular signaling through its regulation of the phosphatidylinositol 4-kinase Pik1p; member of the recoverin/frequenin branch of the EF-hand superfamily
Localization:
Intensity:
Fold change:
Significance:
-
C’ GFP library in SD

punctate29.72 -
N' NOP1pr-GFP in SD

cytosol136.36 -
N' TEF2pr-mCherry in SD
cytosol,punctate225.316 -
N' NATIVEpr-GFP in SD
below threshold20.1465 -
N' TEF2pr-VC and Cyto-VN in SD

cytosol41.0263 -
C’ GFP library in SD+DTT
punctate29.771No -
C’ GFP library in SD+H2O2

punctate20.670.69Yes -
C’ GFP library in Starvation Media
punctate27.550.92No -
C’ GFP library on the background of Pup2-DaMP

punctate -
C’ GFP library on the background of CCT mutant

punctate24.02630.808187No
